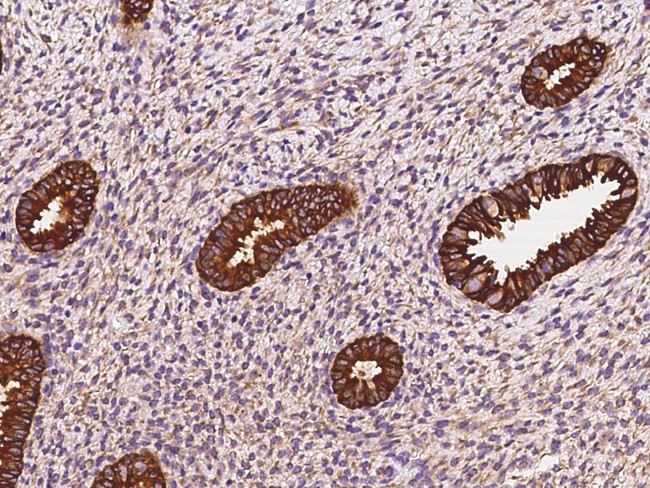
STX18 Antibody in Immunohistochemistry (Paraffin) (IHC (P))

Search
Invitrogen
STX18 Polyclonal Antibody
{{$productOrderCtrl.translations['antibody.pdp.commerceCard.promotion.promotions']}}
{{$productOrderCtrl.translations['antibody.pdp.commerceCard.promotion.viewpromo']}}
{{$productOrderCtrl.translations['antibody.pdp.commerceCard.promotion.promocode']}}: {{promo.promoCode}} {{promo.promoTitle}} {{promo.promoDescription}}. {{$productOrderCtrl.translations['antibody.pdp.commerceCard.promotion.learnmore']}}



Please note: We are reviewing Western blot images included in the antibody testing data in our catalog, including those provided by third parties. Unless expressly labeled or annotated as “raw-unedited”, Western blot images included in the antibody testing data in our catalog may have been edited, optimized or otherwise adjusted for presentation.
产品信息
PA5-112291
种属反应
已发表种属
宿主/亚型
分类
类型
抗原
偶联物
形式
浓度
规格
纯化类型
保存液
内含物
保存条件
运输条件
RRID
靶标信息
Syntaxins, a family of proteins involved in the fusion of synaptic vesicles with the plasma membrane, display broad tissue distribution and contain carboxy-terminal hydrophobic domains that direct themselves to their respective intracellular compartments. Syntaxin 18 mainly localizes to the endoplasmic reticulum (ER), and functions in transport between the ER and Golgi. Syntaxin 18 also plays a role in ER-mediated phagocytosis, possibly by regulating the specific fusion of the ER and plasma or phagosomal membranes.
仅用于科研。不用于诊断过程。未经明确授权不得转售。
生物信息学
蛋白别名: Cell growth-inhibiting gene 9 protein; Syntaxin-18
基因别名: GIG9; STX18
Entrez Gene ID: (Human) 53407